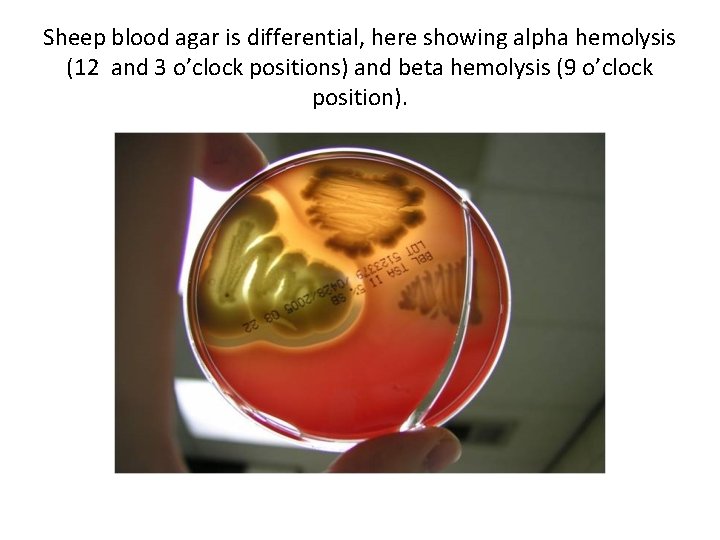
Sheep blood agar is differential, here showing alpha hemolysis (12 and 3 o’clock positions)
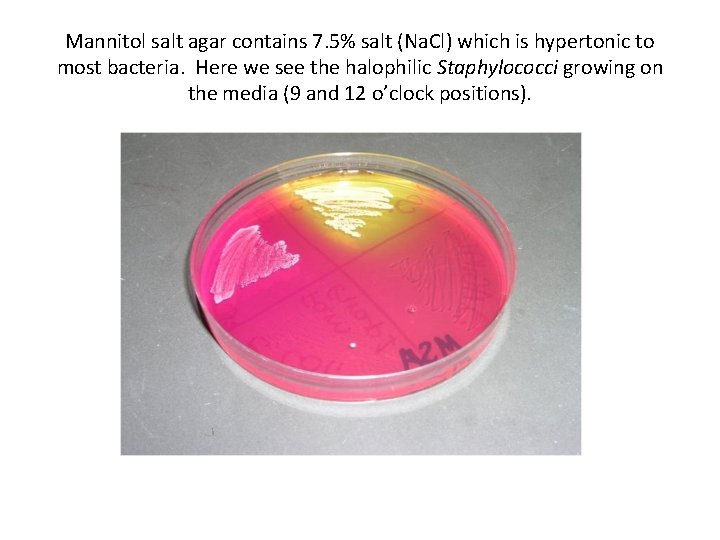
Mannitol salt agar contains 7. 5% salt (Na. Cl) which is hypertonic to most
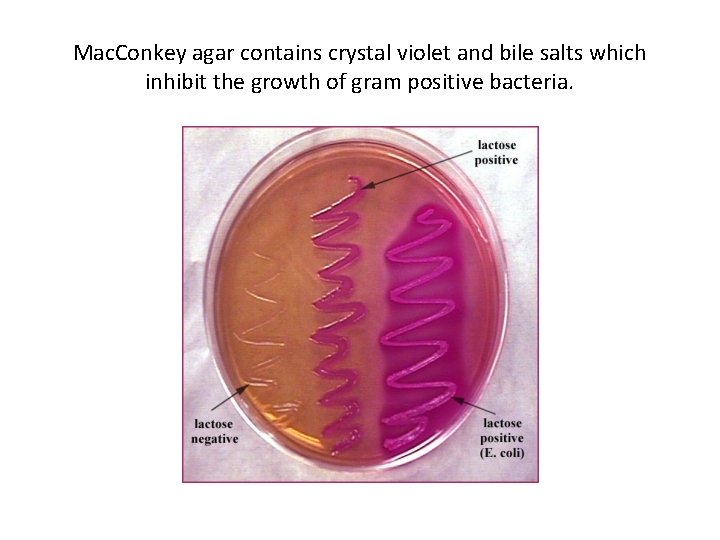
Mac. Conkey agar contains crystal violet and bile salts which inhibit the growth of
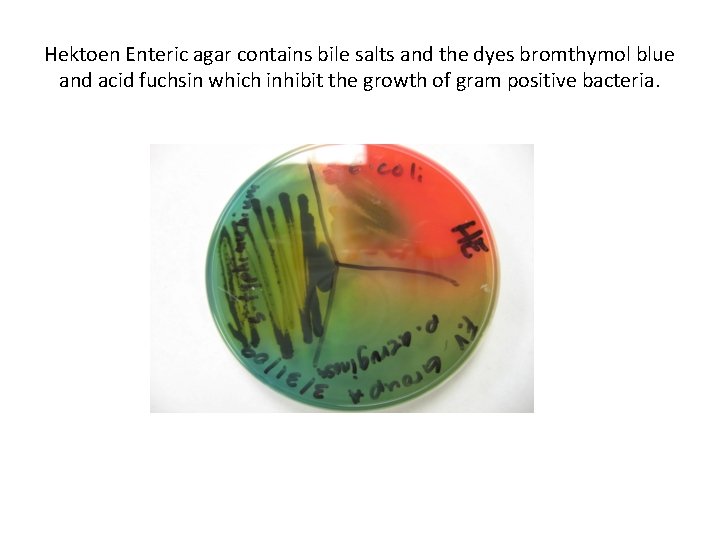
Hektoen Enteric agar contains bile salts and the dyes bromthymol blue and acid fuchsin

LECTURE TEST PACKET 3 Microbial Growth and Destruction

LECTURE TEST PACKET #3 Microbial Growth and Destruction

WHAT ARE THE 8 MAJOR ENVIRONMENTAL FACTORS WHICH EXERT THE GREATEST INFLUENCE ON THE SURVIVAL OF MICROORGANISMS? 1. Nutrients and energy sources 2. Temperature 3. Amount of moisture 4. Presence or absence of gases 5. Osmotic pressure 6. p. H 7. Presence or absence of light or radiation 8. Other organisms

EFFECTS OF ENVIRONMENTAL CONDITIONS ON BACTERIAL GROWTH

The ability to survive in environmental conditions and reproduce is called VIABILITY. (Viable bacteria are alive)

1. TEMPERATURE - there are NO organisms that grow at all temperatures - generally the reason why most organisms cannot survive in very hot environments is because, even though a slight increase in temperature causes faster enzyme reactions, more drastic increases in temperature cause enzymes to denature.

- generally the reason why most organisms cannot grow at low temperatures is because cell membranes lose their fluid nature and this makes ATP production more difficult. - each bacterial species has three (3) important temperatures that are characteristic for that species under given conditions; these three temperatures are a species’ CARDINAL TEMPERATURES; they include the minimum, the maximum and the optimum temperature at which a bacterial species will grow.

Each bacterial species has a series of cardinal temperatures.

Most bacteria will grow if they are in a temperature range that spans 30 -40°C around their optimum growth temperature. The temperature can affect the growth rate, metabolism, morphology, reproduction rate and nutrient requirements of the bacterium. Bacteria are grouped by their temperature affinity into three groups: a) Psychrophiles b) Mesophiles c) Thermophiles

Terms used to describe the temperature affinity of different types of bacteria.

A. PSYCHROPHILES - these grow in oceans, snow fields, glaciers and other constantly cold environments - some can grow in temperatures that approach 0°C - NO bacterial growth occurs in frozen solid conditions, but frozen conditions usually don’t kill many bacteria; instead, in cold, bacteria are in a state of suspended animation - psychrophiles can exist in cold environments because they have high concentrations of unsaturated fatty acids in their phospholipid bilayers of their cell membranes, so that they can maintain some fluidity in the cold - some mesophilic bacteria can also grow in cold environments and are called psychrotolerant

B. MESOPHILES - grow best at 25 -40°C - saprophytes (decomposers) grow best at 25°C - human pathogens grow best at 37°C - Listeria monocytogenes is a psychrotolerant bacterium that causes a type of food poisoning that can lead to miscarriages

C. THERMOPHILES - grow at soil surfaces that get to 50 -70°C, in deserts, electrical power plant water, compost, silage and hot springs - organisms that grow at these temperatures are usually prokaryotes; hyperthermophiles include some archaebacteria - to survive the problem of enzyme denaturation, these bacteria rapidly produce enzymes and use more heat stable amino acids; their cell membranes have higher concentrations of saturated fatty acids than other organisms

2. p. H - in microbial growth media p. H buffers are commonly used to keep the p. H of the media relatively constant (around 7), since microbes often produce wastes that can change the p. H of their environment resulting in death - in microbiological media that are differential, p. H indicators are commonly employed to distinguish between bacterial species and to detect the enzymes that the bacteria contain

Different bacteria have various p. H affinities (acidophiles, neutralophiles and alkalophiles); fungi appear to be more acid tolerant than bacteria.

3. WATER AVAILABILITY - all organisms need water to survive - know the definition of osmosis - Plasmolysis is the loss of water from cells placed in a hypertonic solution (high salt or sugar for example); it causes the cell membrane to shrink from the cell wall and may result in cell death - In cells without a cell wall (like your RBC’s) this shrinkage is called crenation

Bacterial and plant cells (cells with cell walls) undergo plasmolysis in a hypertonic solution; cells without cell walls (such as animal cells) undergo crenation in a hypertonic solution.

A) HALOPHILES - like salt - Staphylococcus spp. B) OSMOPHILES - like solutes like sugar - fungi like higher sugar concentrations than most bacteria C) XEROPHILES - can survive in arid (dry) conditions - they use compatible intracellular solutes to absorb any available water from their environment

The pink pigment of this lake is due to halophilic bacteria Mannitol salt agar is selective for the growth of halophilic bacteria

Xerophile “desert varnish” discolors boulders in a desert

4. OXYGEN REQUIREMENTS - our atmosphere has approximately 18 -21% O₂ (about 78% is N₂) - to test for the oxygen requirements for each bacterial species, we can use media such as fluid thioglycollate media (FTM) - FTM contains the pink dye resazurin to detect the presence of O₂ - different levels in the media have different concentrations of O₂ (at the top there atmospheric concentrations, at the bottom there is no O₂)

FTM showing different types of bacteria and their need for different concentrations of O₂

A) STRICT (OBLIGATE) AEROBES - these organisms produce toxic H₂O₂ intracellularly as a result of aerobic cellular respiration - aerobes have enzymes (catalase, peroxidase) to remove the toxic hydrogen peroxide from their cells -the CATALASE test is used in common bacterial identification schemes and detects the presence of this enzyme 2 H₂O₂ + catalase 2 H₂O + O₂ (bubbles) - the catalase test is an easy way to distinguish Staphylococcus spp from Streptococcus spp

CATALASE TEST after adding hydrogen peroxide, oxygen bubbles are produced by bacteria that produce the enzyme catalase Media test Slide test

B) FACULTATIVE ANAEROBES - grow better with O₂ but can survive when it is absent C) MICROAEROPHILES - these bacteria like O₂ concentrations between 1% - 15%

D) STRICT (OBLIGATE) ANAEROBES - these bacteria are killed in the presence of O₂ - Clostridium spp are often strict anaerobes - they can be found in areas such as the oral cavity (deep under the gum line), in bite wounds, canned foods, oil fields, mud and peat bogs

Anaerobic environments suitable for strict anaerobes. Home “canning” uses mason jars Gas gangrene in a shoulder wound

MICROBIAL NUTRITION AND ENERGY SOURCES

How do bacteria obtain nutrients (substances obtained from the environment used for metabolism? - most are absorptive heterotrophs (they secrete their enzymes outside the cell to digest macromolecules into organic building blocks and then absorb the organic building block materials to use for their own metabolism) - in lab, we tested this concept on starch agar, milk agar and tributyrin agar plates

A. MACRONUTRIENTS - these are nutrients needed in very large amounts - approximately 96% of the cell is made of the elements C, H, O, N, P and S

1. CARBON - carbon is needed to make all organic molecules (ATP, Nucleic Acids, Protein, Carbohydrates, Lipids) - HETEROTROPHS get their carbon from other organisms - chemoheterotrophs also get their energy from other organisms - photoheterotrophs use light as their energy source - AUTOTROPHS get their carbon from CO₂ - chemoautotrophs get their energy from inorganic compounds; they are called “lithotrophs” when they use minerals as their energy source - photoautotrophs get their energy from light

2. HYDROGEN - hydrogen is found in water and all organic molecules - hydrogen ions are needed to maintain p. H levels - hydrogen is needed to for hydrogen bonds - hydrogen ions when they form a gradient on opposite sides of a phospholipid bilayer membrane can be used to make ATP

3. NITROGEN - even though 78% of our atmosphere is nitrogen gas (N₂), plants and animals are unable to use this source of nitrogen directly; on the other hand, bacteria are able to use the atmospheric N₂ and can “fix” the nitrogen in a process called nitrogen fixation (the N₂ is converted to a form of nitrogen the plant can use as fertilizer) - nitrogen is needed to make ATP, proteins, DNA, RNA, and peptidoglycan

The Nitrogen Cycle Nitrogen fixation, performed by bacteria, transforms atmospheric nitrogen gas into a form of nitrogen plants can use.

4. OXYGEN - oxygen is needed for cell respiration, to make ATP; it is the final electron acceptor in the electron transport chain - oxygen is found in water, the universal solvent in the cytoplasm of cells

5. PHOSPHORUS - phosphorus is found in nucleic acids, ATP and phospholipids - it is one of the main ingredients plants use up in the soil and is found in fertilizers, along with nitrogen and potassium

Fertilizer label

6. SULFUR - is found in the amino acid cysteine and is important in tertiary protein structure (disulfide bridges)

7. OTHER MACRONUTRIENTS include: K, Na, Ca, Mg, Cl and Fe are needed in large amounts but not in near as large amounts as the major 6 macronutrients

B. MICRONUTRIENTS - are also called trace elements and they are needed in smaller quantities for enzyme and pigment structure and function - they include: Mn, Zn, Mo, Cu, Co, Ni, W, Se

VITAMIN/MINERAL SUPPLEMENT LABEL

CULTURE MEDIA

Media are substances on or in which we grow bacteria and it can be either: SYNTHETIC (chemically defined) – where we know precisely the identity and amount of every component in the media COMPLEX(chemically undefined, nonsynthetic) – not all components in the media are known - for example: blood agar, TSA, milk agar, yeast extract broth

Media can be either a solid or a liquid broth Agar is the inert gel, made from a red algae, that doesn’t melt in the incubator temperatures and isn’t used by bacteria as a nutrient source. (this is why gelatin isn’t used to solidify most bacteriologic media; gelatin melts at 25°C and is used by some microbes as a nutrient source, when it is digested it liquefies)

Agar is used to solidify most media in microbiology. Broth can also used to grow bacteria.

There are four basic types of bacterial growth media: 1. GENERAL PURPOSE MEDIA - this is media used to grow as many types of bacteria as is possible; most bacteria can grow on it - Nutrient broth (NB), nutrient agar (NA) - Trypticase Soy broth (TSB), trypticase soy agar (TSA)

Trypticase Soy agar is a commonly used general purpose medium.

2. ENRICHED MEDIA - this is general purpose media with added growth factors (compounds such as vitamins and amino acids which some bacteria are unable to make on their own) - organisms that require growth factors are termed “fastidious” - Chocolate agar - Sheep Blood agar (BA)

From where do we get chocolate agar? Chocolate agar cube Chocolate agar is used to grow Neisseria gonorrhoeae
Sheep blood agar is differential, here showing alpha hemolysis (12 and 3 o’clock positions) and beta hemolysis (9 o’clock position).

3. SELECTIVE MEDIA - media containing an agent (chemical) or agents that inhibits the growth of some microbes while allowing others (which we want to select) to grow - Mannitol Salt agar (MSA) - Eosin Methylene Blue agar (EMB) - Mac. Conkey agar (MAC) - Hektoen Enteric agar (HEA)
Mannitol salt agar contains 7. 5% salt (Na. Cl) which is hypertonic to most bacteria. Here we see the halophilic Staphylococci growing on the media (9 and 12 o’clock positions).

Eosin Methylene Blue agar contains the dyes eosin and methylene blue, which inhibit the growth of gram positive bacteria.
Mac. Conkey agar contains crystal violet and bile salts which inhibit the growth of gram positive bacteria.
Hektoen Enteric agar contains bile salts and the dyes bromthymol blue and acid fuchsin which inhibit the growth of gram positive bacteria.

4. DIFFERENTIAL MEDIA - media that can support the growth of several types of bacteria, but on which different bacteria either appear differently (different colors) or where different bacteria cause the media to appear differently - MSA, EMB, BA, Mac. Conkey and HEA are all also differential media

Mannitol salt agar is differential due to mannitol and the phenol red p. H indicator; Staphylococcus aureus produces acid from mannitol fermentation (yellow) and Staphylococcus epidermidis doesn’t (pink)

Eosin Methylene Blue agar is differential according to a microbe’s ability to ferment lactose (to produce acid) and due to the two dyes; large amounts of acid account for the metallic green sheen of E. coliforms, smaller amounts of acid account for pink coliforms. Non- coliforms produce clear colonies.

Blood agar is differential depending on the ability of a microbe to produce hemolysins. Complete RBC lysis and hemoglobin breakdown account for the zone of clearing (beta hemolysis); partial hemoglobin break down results in the media looking a drab (green-brown) (alpha hemolysis) while no RBC destruction is called gamma hemolysis.

Mac. Conkey agar is differential when lactose is fermented to produce acid which affects the p. H indicator neutral red. Coliforms (lactose fermenting enterics) produce pink colonies, E. coli produces so much acid that the media around the colonies also turns pink. Non-coliforms are colorless.

Hektoen Enteric agar is differential due to the ability of microbes to produce acid from lactose/sucrose fermentation (orange colonies and media) or not produce acid (blue-green colonies). The media also differentiates the non-coliforms Salmonella (black ppt due to H₂S production) vs. Shigella (no black ppt).

MICROBIAL GROWTH

- Refers to increases in the numbers of cells in a culture, not the growth in size of individual cells - it is based primarily on nutrient availability, but is influenced by other factors - it happens due to binary fission (asexual bacterial reproduction that produces clones) - the length of time it takes for one bacterial cell to undergo binary fission (for one cell to become two) is called the generation rate (doubling time)

Bacteria growing in a closed system (limited nutrients) typically show a pattern of growth represented by the following growth curve.

LAG PHASE - no net growth, although the cells are active physiologically, there is no binary fission. LOG (EXPONENTIAL) GROWTH PHASE – bacterial cells are dividing at their generation time; this is when gram staining is most successful, and when antibiotics, like penicillin, are most effective. STATIONARY PHASE – the bacterial cells are now starting to die off in equal numbers to the number of cells dividing due to reduced nutrient levels and due to increased wastes.

DEATH (LOGRITHMIC DECLINE) PHASE – cells are now dying off due to lack of nutrients and buildup of wastes. If you were given a bacterial culture and were asked to keep it alive for months, what are some of the ways that you could do this? 1. Temperature: refrigeration or freezing suspends bacterial growth. 2. Subculturing: this is when you inoculate new sterile media with microbes from an old bacterial culture. 3. Continuous culturing is done using a chemostat, a device used to continually resupply bacteria with fresh nutrients and gases while removing wastes.

Chemostat schematic diagram

BACTERIAL CELLULAR METABOLISM

Review your chemistry homework and be able to define: ANABOLIC REACTIONS CATABOLIC REACTIONS

A. Most all chemical reactions in living organisms are controlled by ENZYMES. - enzymes are the protein catalysts, produced from the DNA code, that allow the chemical reactions to occur in your body at body temperature; without them you would not be able to live - enzymes are biological catalysts that speed up chemical reactions (by some estimates by a factor of 10²³ times faster than would occur naturally) and they are reusable 10²¹ = a sextillion; 10²⁴ = a septillion

- molecules that are enzymes have names that end in the suffix –ase (catalase, lysine decarboxylase, DNA polymerase) - enzymes are very specific; each enzyme acts upon only one set of substrates (reactants in a chemical reaction) - enzymes link up to their substrates at a spot on the enzyme known as the active site - enzymes can be denatured by increases in temperature, by p. H changes and by changes in osmotic pressure - some microbes use enzymes as pathogenic factors to cause disease (ringworm uses keratinase)


PHOTOSYNTHESIS

When does photosynthesis occur in most plants? Daytime? Nighttime? All the time? OXYGENIC PHOTOSYNTHESIS - occurs in plants, algae and in cyanobacteria which all use similar pathways using chlorophyll A - CO₂ + H₂O Glucose + O₂ - Do plants need the O₂ gas they made in photosynthesis?

PHOTOSYNTHESIS

- in most plants photosynthesis occurs in the DAYTIME only - the GLUCOSE and the OXYGEN made via photosynthesis are used BY THE PLANT in plant cell mitochondria to make ATP for the plant cell through the process of aerobic cellular respiration

ANOXYGENIC PHOTOSYNTHESIS - photosynthetic purple and green bacteria contain a slightly different sunlight energy absorbing molecule called bacteriochlorophyll - these bacteria DO NOT produce O₂ gas their photosynthesis, because they do not split water. - instead of using water as a source of electrons to make ATP (ATP is needed to perform photosynthesis), these bacteria use H₂ gas, H₂S gas or elemental sulfur as sources of electrons to make ATP; none of these have any oxygen molecules to release (in oxygenic photosynthesis, water is split and the hydrogen ions are used to make ATP as the oxygen molecules are released as O₂ )

AEROBIC CELLULAR RESPIRATION

The catabolism of glucose in the presence of O₂ gas proceeds in three steps: GLYCOLYSIS (the splitting of glucose to 2 pyruvates) KREBS CYCLE (citric acid cycle) ELECTRON TRANSPORT SYSTEM

Aerobic cellular respiration occurs in 3 steps: Glycolysis, Krebs cycle and Electron transport chain

WHY DO BACTERIA AND EUKARYOTIC CELLS PRODUCE DIFFERENT AMOUNTS OF ATP FROM ONE MOLECULE OF GLUCOSE? - bacteria generally make 38 ATP molecules from each molecule of glucose catabolized in cell respiration, but eukaryotic cells generally produce only 36 ATP molecules from glucose using the same pathway!!

Eukaryotic aerobic cellular respiration

The reason is since eukaryotic cells have mitochondria, the 2 NADH molecules produced in glycolysis must travel into the mitochondria to be processed in the electron transport system. This doesn’t occur in the prokaryotic cells where all of the chemical reactions occur side by side. In eukaryotes, each NADH that moves into the mitochondria will need to use one ATP to pass through the mitochondrial membranes and enter the organelle. Therefore, eukaryotes lose a net 2 ATP and result in less ATP being produced than in prokaryotes.

FERMENTATION

- this is the fate of the pyruvic acid produced in glycolysis if no oxygen gas is present - besides the 2 ATP made through glycolysis, there is no further ATP production when no oxygen gas is present - the pyruvic acid produced from glucose through glycolysis can be further metabolized through several pathways: a) ethyl alcohol fermentation b) lactic acid fermentation c) mixed acid fermentation

Ethanol (ethyl alcohol) fermentation - the pyruvic acid (pyruvate) is manufactured from glucose through glycolysis

Ethanol fermentation occurs when yeast (Saccharomyces) ferment sugars to make beer, wine and bread.

The 2 pyruvic acid molecules made through glycolysis of glucose can be fermented by bacterial species to make lactic acid.

Yogurt and cheese are made with lactic acid producing bacteria. Sourdough bread is made with lactic acid producing bacteria.

Lactic acid producing bacteria are used to make many foods like pickles and fermented cabbage (sauerkraut).

Lactic acid fermentation is what makes you feel your muscles “burn” during aerobic exercise; due to the need for even more ATP than can be produced aerobically, your muscles make ATP anaerobically for a short time.

Mixed acid fermenting bacteria can be positively identified with the Methyl Red test. A positive test indicates the bacteria can ferment glucose and make large amounts of stable mixed acids.

CONTROL OF MICROBIAL GROWTH go to Lecture Packet 3 – part B power points
- Slides: 92